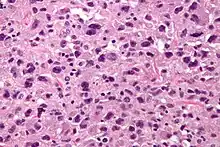

Undifferentiated pleomorphic sarcoma
| Undifferentiated pleomorphic sarcoma | |
|---|---|
| Other names | Pleomorphic myofibrosarcoma, high-grade myofibroblastic sarcoma, and high-grade myofibrosarcoma |
| |
| Micrograph of undifferentiated pleomorphic sarcoma (H&E stain) | |
| Specialty | Oncology |
| Causes | Unknown |
| Prognosis | Guarded |
| Frequency | Rare |
Undifferentiated pleomorphic sarcoma (UPS), also termed pleomorphic myofibrosarcoma,[1] high-grade myofibroblastic sarcoma, and high-grade myofibrosarcoma,[2] is characterized by the World Health Organization (WHO) as a rare, poorly differentiated neoplasm (i.e., an abnormal growth of cells that have an unclear identity and/or cell of origin).[3] WHO classified it as one of the undifferentiated/unclassified sarcomas in the category of tumors of uncertain differentiation.[4] Sarcomas are cancers derived mesenchymal stem cells that typically develop in bone, muscle, fat, blood vessels, lymphatic vessels, tendons, and ligaments.[5] More than 70 sarcoma subtypes have been described.[6] The UPS subtype of these sarcomas consists of tumor cells that are poorly differentiated and may appear as spindle-shaped cells, histiocytes, and giant cells.[7] UPS is considered a diagnosis that defies formal sub-classification after thorough histologic, immunohistochemical, and ultrastructural examinations fail to identify the type of cells involved.[8]
The diagnosis of UPS initially included the malignant fibrous histiocytomas (MFH).[1] MFH are now regarded as a wastebasket category of various sarcoma types including sarcoma-like carcinomas and melanomas.[9] Studies strongly suggest that MFH tumors are not derived from histiocytes (cells descended from blood monocytes),[9] but rather from mesenchymal cells.[1] UPS had also been regarded as a more aggressive and metastasizing form of the low-grade myofibroblastic sarcomas and intermediate‐grade myofibroblasic sarcomas.[1] WHO has combined low- and intermediate-grade myofibroblastic sarcomas into a single entity, low-grade myofibroblastic sarcomas, and categorized it as one type of the intermediate (rarely metastasizing) fibroblastic and myofibroblastic tumors quite distinct from UPS.[10] Because of their low incidence and frequent grouping with what are now considered to be other sarcoma types, past findings on the clinical behaviour, proper treatment, and prognosis of UPS may be revised with further study.[8]
The majority of UPS tumors are highly aggressive, often recur after surgical removal, and often metastasize.[11] They are treated with a combination of surgical resection, radiotherapy, and/or chemotherapy.[6] More recently, UPS tumors have been treated with antibody therapy, i.e. antibodies which in the case of UPS bind to specific antigens on the surface of T-cells (a type of lymphocyte) and thereby promote the ability of these T-cells to organizes an attack on UPS tumor cells.[12]
Presentation
UPS commonly presents as a deep-seated, rapidly enlarging, painless mass in individuals aged 50 to 70 years. These masses are rarely superficial lesions and rarely occur in the pediatric population.[11] In a retrospective study of 266 individuals, UPS tumors ranged from 1–55 cm in greatest diameter (average 8.8 cm with 25%, 38%, and 38% having greatest diameters of 0–1, 5–9, and ≥10 cm, respectively).[13] In a study of 205 individuals (median age 59 years) diagnosed with UPS, the tumors were located in the arm or leg (47.3% of cases), abdomen or pelvis (26.8%), thorax (17.6%), and head or neck (8.3%) areas.[8] In rare cases, these tumors have also presented in other sites such as the retroperitoneal space,[14] liver,[15] pleura of the lung,[2] heart,[16][17] and small intestine.[17] In a retrospective study, distant metastases were detected at the time of initial diagnosis in 6.4% of 266 individuals.[13] Overall, metastases have or will develop in up to 40% of individuals with UPS.[18] These metastases are reported to occur in lung (40%[13] to 55%[14] of cases) and less commonly in other sites such as lymph nodes near the primary tumor,[19] brain,[20] pancreas,[21] and heart.[22]
Neoplastic fever
A review study conducted in China of 183 individuals with UPS reported that 7 (3.83%) individuals (age 51 to 73 years; median age 62.8 years) had a subtype of the paraneoplastic syndrome termed neoplastic fever, i.e. these individuals suffered continuous, disabling fevers. Their tumors were located within a thigh muscle (4 cases), the upper arm (2 cases), or the lower leg (1 case). Compared to 89 individuals (median age 59.1 years) with a similar distribution of their UPS tumors, individuals with the neoplastic syndrome had similar tumor recurrence rates (57.14% vs 53.93% for the two respective groups) but a lower metastasis rate (14.29% vs 44.94%) and a higher 3-year survival rate (85.71% vs 59.55%). Fever symptoms disappeared in all patients after surgical removal of their tumors. It is suggested that individuals with UPS and neoplastic fever have a more favorable prognosis than individuals with UPS that do not evidence such fevers.[7]
Pathology
UPS is a diagnosis of exclusion (a diagnosis reached by the process of elimination) because the histopathology of this disorder's tumors is non-specific. UPS tumor cells are undifferentiated (i.e. do not resemble any particular cell type) and pleomorphic (i.e. highly variable in size, shape, and/or color) when examined microscopically. Therefore, the diagnosis of UPS is commonly based on detecting a specific set of proteins that are expressed by UPS tumor cells but not by the cells of other undifferentiated and pleomorphic tumors or visa versa (see Diagnosis section).[11]
A study of 52 individuals found that their UPS tumor cells expressed on their surface membranes PD-L1 protein (i.e. programmed death-ligand 1 protein) either focally (36.5% of cases) or strongly (9.62% of cases); 48.1% of these individuals had tumor cells which also expressed IDO1 protein (i.e. indoleamine 2,3-dioxygenase protein).[23] Tumor cells that strongly expressed PD-L1 also expressed CMTM6 protein (i.e. CKLF like MARVEL transmembrane domain containing 6 protein).[24] Strong PD‑L1 expression proved to be a poor, while expression of IDO‑1 proved to be a favorable, prognostic factor for disease outcomes.[23] Individuals with tumor cells that strongly expressed CMTM6 protein also had poor prognoses. Increases in the expression of CMTM6 protein were associated in some cases with mutations that increased the number of copies of its gene, i.e. CMTM6.[25] In a later study that examined 83 individuals, 72.8% had UPS tumor cells that expressed PD-L1 with 53%, 35%, and 12% of these cases showing weak, intermediate, and strong PD-L1 expression, respectively.[8] And, in a study of 73 patients with UPS, 39 cases showed no, 23 cases showed low, 10 showed intermediate, and 11 strong immunoreactivity for AMPD2, i.e. AMP deaminase 2 protein; the gains in AMPD2 protein immunoreactivity were associated with copy number gains in the AMPD2 gene and patients with higher AMPD2 levels had poorer prognoses (5 year survivals for AMPD2 positive versus AMPD2 negative cases were ~38 and 59%, respectively).[26] Other abnormalities found in some or isolated cases of UPS include: 1) Amplification of the Hippo signaling pathway, an intracellular cell signaling pathway that regulates cell proliferation and cell death;[27] this amplification is associated with the overexpression of two proteins, vestigial-like family member 3 protein, a product of the VGLL3 gene, and YAP1, i.e. yes-associated protein 1, a product of the YAP1 gene, in the Hippo signaling pathway; 2) Abnormal activation of notch signaling pathways (this activation has been shown to promote the growth and survival of various types of cancer cells;[28] and 3) Overexpression of DKK1, i.e. Dickkopf-related protein 1 (elevated in the tumor cells of various cancer types).[29]
UPS tumors also show gene and chromosome abnormalities that further studies may find contribute to the development and/or progression of UPS. These abnormalities, which have not yet been reported to be helpful in diagnosing UPS, include the following. 1) Deletion and/or inactivation or the RB1 gene that encodes (i.e. is responsible for production of) the retinoblastoma protein that functions as a tumor suppressor protein; 2) deletions and/or mutations in the TP53 gene that encodes tumor protein P53 (a protein which regulates cell proliferation and cell death); 3) mutations in the ATRX gene that encodes transcriptional regulator ATRX protein which contributes to regulating the expression of various genes;[30][31][32] 4) mutations in the KMT2C gene which encodes lysine N-methyltransferase 2C protein (the KMT2C gene is mutated in various cancer types[33]); 5) amplification of the IL7R gene which encodes Interleukin-7 receptor-α protein (mutations in the IL7R gene are commonly found in acute lymphoblastic leukemia[34])[31] and 6) expression of a fusion gene (i.e. a hybrid gene formed from two previously independent genes as a result of a mutation) that merges TRIO with other genes and is often found in other sarcoma subtypes.)[30]
Diagnosis
The diagnosis of UPS depends on finding non-specific, undifferentiated tumor cells that have features suggestive of UPS and not features of other tumor types that also consist of pleomorphic, undifferentiated cells. The features primarily involve the expression of certain proteins by the tumor cells. The identifying proteins for UPS tumor cells are given in the preceding section. Identification proteins for tumors that have been confused with UPS inlclude:[11]
- Pleomorphic leimyosarcoma: Desmin and h-caldesmon (i.e. high molecular form of caldesmon.[35]) proteins
- Pleomorphic rhabdomyosarcoma: Desmin and myogenin proteins.
- Defifferentiated liposarcoma: MDM2 and CDK4 proteins.
- Poorly differentiated carcinoma (i.e. grade 3 or 4 carcinoma): MUC1 (also termed EMA), TP63 (also termed p63; which is detected with the p40 antibody[36]), and various members of the keratin family of proteins.
- Melanoma: MLANA (i.e. melanoma antigen recognized by T cells 1 protein), S100, and PMEL (a product of the PMEL gene which is detected using an antibody termed HMB-45.[37]) proteins
Two other tumors that may be confused with UPS have microscopic histopathological and/or other features that help make this distinction. These tumors and features are:[11]
- Pleomorphic liposarcoma: At least some tumor cells have features of pleomorphic lipoblasts, i.e. variable shaped immature fat cells.
- Malignant peripheral nerve sheath tumor: Typically occurs in young children, often develops in a preexisting inoperable plexiform neurofibroma, and often associated with neural tissue. These tumors typically show undifferentiated, pleomorphic cells that are arranged in whorls, parallel bundles, or rosettes (i.e. circular arrangement resembling leaves in a flowering plant) and often contain large areas of necrosis (i.e. dead or dying cells).
Treatment and prognosis
The most often used treatment for localized (i.e. no metastases) UPS tumors is complete surgical removal with the object of leaving no tumor cells behind as evidenced by microscopic examinations. Adjuvant therapy combining radiotherapy or/and chemotherapy with surgical resection is employed to reduce the risk of developing recurrent and metastatic disease in cases with high-risk disease (e.g. large tumors, tumors deemed highly aggressive based on their pathology and/or local invasiveness, inoperable tumors, and resections that did not remove all tumor cells).[8] A standard chemotherapy two-drug regimen (epirubicin plus ifosfamide) may be used in these cases.[38] In place or combined with surgery and/or radiotherapy, severe and/or metastatic cases of UPS are commonly treated with epirubicin plus ifosfamide; doxorubicin alone or combined with ifosfamide, olaratumab, trabectedin, gemcitabine, or docetaxel;[11] cyclophosphamide, vincristine, doxorubicin, plus dacarbazine or cisplatin; cyclophosphamide, doxorubicin, plus dacarbazine; high dose methotrexate; or etoposide, ifosfamide, and cisplatin.[8] These treatment regimens have been reported to lower local recurrence rates,[13] prolong disease-free survival rates (i.e. time after treatment when no disease is detected),[38] and increase overall survival rates (i.e. time after treatment to death from any cause).[11] However, other studies report that the addition of radiotherapy and/or chemotherapy to surgical resection does not improve recurrence or overall survival rates;[8] addition of radiotherapy to surgery improves local control of UPS tumors but not disease-free survival rates (i.e. time from treatment to recurrence of disease);[6] and adjuvant chemotherapy and radiotherapy have no significant effects on local recurrence-free survival rates, metastasis-free survival times, and overall survival rates.[14] Further studies are needed to define the best treatments for UPS tumors.[38]
In a retrospective study of 176 patients with localized UPS undergoing curative-intent treated with surgical resection or resection plus adjuvant treatment, disease-free survival rates at 120 months for patients with tumors in an extremity (leg or arm), heat/neck area, thorax, and abdomen/pelvis were about 70, 60, 50, and 0%, respectively; overall survival rates at 150 months for disease at these sites were about 90, 80, 75, and 35%, respectively. Patients who received surgery alone or surgery plus adjuvant treatment had disease-free survival rates of about 50 and 40%, respectively.[8] A retrospective analysis of 266 patients with UPS were treated with surgery alone (6% of cases), surgery plus radiotherapy (91% of cases), or surgery plus chemotherapy (3% of cases). Post-treatment local recurrences and metastases were observed in 15% and 38% of cases; 5- and 10-year overall survival rates were 60% and 48%, respectively; Overall median survival time were 10.1 years; and patients with tumors ≥10 cm in longest diameter had an almost 6-fold higher rate of developing metastases than patients with tumors 4 cm or smaller. Poorer prognoses were seen in older patients; in patients with tumors that were large-sized, deep-seated, and/or located in a leg; in patients that presented with metastases; and in patients who had positive surgical margins and/or developed local recurrences after surgery.[13] In another retrospective study, 203 individuals with UPS, 141 of whom had metastatic disease, were treated with regimens selected based on the severity of their disease. In this study, the overall 5 year survival rate was 4%. Patients with the most advanced disease had a median overall survival time 11 months.[39]
Immunotherapy
Recent studies have treated UPS by targeting the immune system with pembrolizumab.[12] Pembrolizumab is a manufactured IG4 therapeutic monoclonal antibody that binds to and inhibits stimulation of the PD-1 receptors expressed on the surface of activated T-cells. This inhibition blocks the PD-L1 and PL-L2 ligands located on the surface of normal tissue cells from binding to PD-1 receptors on activated T-cells and thereby blocks the T-cells from organizing an inflammatory response that kills the normal cells. Tumor cells may use this inflammation-evading tactic: they may express PD-L1/PD-L2 and thereby block the T-cell-mediated immune responses to them (see Immune checkpoint).[40] From ~47%[23] to ~73%[8] of UPS cases contain tumor cells that express PD-L1. In a retrospective review of 10 patients with UPS, 1 patient had a complete response, 3 had partial responses, and 6 had no response to pembrolizumab.[12] (Further studies of the 4 pembrolizumab-responsive patients indicated that their tumor cells expressed PD-L1 in two cases but not in the other two cases.[41]) In a retrospective study of 25 patients (21 patients treated with pembrolizumab, 4 treated with other immunotherapy agents), 7 attained stable disease, 7 attained partial responses, and 1 attained a complete response.[42] In a study of 16 patients with UPS, 5 achieved short-term (lasting 1.2 to 1.4 months) stable disease in response to a regimen of pembrolizumab combined with the chemotherapy drug, cyclophosphamide.[43] It is clear that new treatment strategies[18] as well as further studies on the efficacy of pembrolizumab and similarly acting immunotherapy drugs used with or without radiotherapy and/or chemotherapy over longer time periods are needed to evaluate their usefulness in treating UPS.[44]
References
- 1 2 3 4 Fisher C (September 2004). "Myofibrosarcoma". Virchows Archiv. 445 (3): 215–23. doi:10.1007/s00428-004-1038-9. PMID 15173943. S2CID 220565385.
- 1 2 Zhao R, Wang J, Zhang H, Chi Y, Bi N (October 2020). "High-grade myofibroblastic sarcoma of the pleura: A case report and literature review". Thoracic Cancer. 11 (10): 3011–3014. doi:10.1111/1759-7714.13613. PMC 7529570. PMID 32815307.
- ↑ Renn A, Adejolu M, Messiou C, Bhaludin B, Strauss DC, Thway K, Moskovic E (December 2021). "Overview of malignant soft-tissue sarcomas of the limbs". Clinical Radiology. 76 (12): 940.e1–940.e16. doi:10.1016/j.crad.2021.08.011. PMID 34607656. S2CID 238357489.
- ↑ Choi JH, Ro JY (January 2021). "The 2020 WHO Classification of Tumors of Soft Tissue: Selected Changes and New Entities". Advances in Anatomic Pathology. 28 (1): 44–58. doi:10.1097/PAP.0000000000000284. PMID 32960834. S2CID 221862064.
- ↑ "What Is Cancer?". National Cancer Institute. 2007-09-17. Retrieved 2017-11-26.
- 1 2 3 Kamat NV, Million L, Yao DH, Donaldson SS, Mohler DG, van de Rijn M, Avedian RS, Kapp DS, Ganjoo KN (February 2019). "The Outcome of Patients With Localized Undifferentiated Pleomorphic Sarcoma of the Lower Extremity Treated at Stanford University". American Journal of Clinical Oncology. 42 (2): 166–171. doi:10.1097/COC.0000000000000496. PMID 30557163. S2CID 56178938.
- 1 2 Wang J, Dong S, Zhang J, Gao S, Li Z, Li P, Yuan J, Tian Z (2021). "Undifferentiated Pleomorphic Sarcoma with Neoplastic Fever: A Retrospective Study". Cancer Management and Research. 13: 8481–8487. doi:10.2147/CMAR.S339278. PMC 8592396. PMID 34795527.
- 1 2 3 4 5 6 7 8 9 Lee K, Song JS, Kim JE, Kim W, Song SY, Lee MH, Chung HW, Cho KJ, Lee JS, Ahn JH (July 2020). "The clinical outcomes of undifferentiated pleomorphic sarcoma (UPS): A single-centre experience of two decades with the assessment of PD-L1 expressions". European Journal of Surgical Oncology. 46 (7): 1287–1293. doi:10.1016/j.ejso.2020.02.029. PMID 32127249. S2CID 212406069.
- 1 2 Hornick JL (January 2020). "Cutaneous soft tissue tumors: how do we make sense of fibrous and "fibrohistiocytic" tumors with confusing names and similar appearances?". Modern Pathology. 33 (Suppl 1): 56–65. doi:10.1038/s41379-019-0388-4. PMID 31653978. S2CID 204886468.
- ↑ Sbaraglia M, Bellan E, Dei Tos AP (April 2021). "The 2020 WHO Classification of Soft Tissue Tumours: news and perspectives". Pathologica. 113 (2): 70–84. doi:10.32074/1591-951X-213. PMC 8167394. PMID 33179614.
- 1 2 3 4 5 6 7 Widemann BC, Italiano A (January 2018). "Biology and Management of Undifferentiated Pleomorphic Sarcoma, Myxofibrosarcoma, and Malignant Peripheral Nerve Sheath Tumors: State of the Art and Perspectives". Journal of Clinical Oncology. 36 (2): 160–167. doi:10.1200/JCO.2017.75.3467. PMC 5759316. PMID 29220302.
- 1 2 3 Tawbi HA, Burgess M, Bolejack V, Van Tine BA, Schuetze SM, Hu J, D'Angelo S, Attia S, Riedel RF, Priebat DA, Movva S, Davis LE, Okuno SH, Reed DR, Crowley J, Butterfield LH, Salazar R, Rodriguez-Canales J, Lazar AJ, Wistuba II, Baker LH, Maki RG, Reinke D, Patel S (November 2017). "Pembrolizumab in advanced soft-tissue sarcoma and bone sarcoma (SARC028): a multicentre, two-cohort, single-arm, open-label, phase 2 trial". The Lancet. Oncology. 18 (11): 1493–1501. doi:10.1016/S1470-2045(17)30624-1. PMC 7939029. PMID 28988646.
- 1 2 3 4 5 Vodanovich DA, Spelman T, May D, Slavin J, Choong PF (September 2019). "Predicting the prognosis of undifferentiated pleomorphic soft tissue sarcoma: a 20-year experience of 266 cases". ANZ Journal of Surgery. 89 (9): 1045–1050. doi:10.1111/ans.15348. hdl:11343/286224. PMID 31364245. S2CID 198997759.
- 1 2 3 Chen S, Huang W, Luo P, Cai W, Yang L, Sun Z, Zheng B, Yan W, Wang C (2019). "Undifferentiated Pleomorphic Sarcoma: Long-Term Follow-Up from a Large Institution". Cancer Management and Research. 11: 10001–10009. doi:10.2147/CMAR.S226896. PMC 6885560. PMID 31819633.
- ↑ Wen J, Zhao W, Li C, Shen JY, Wen TF (October 2017). "High-grade myofibroblastic sarcoma in the liver: A case report". World Journal of Gastroenterology. 23 (38): 7054–7058. doi:10.3748/wjg.v23.i38.7054. PMC 5658323. PMID 29097878.
- ↑ Oh SJ, Yeom SY, Kim KH (May 2013). "Clinical implication of surgical resection for the rare cardiac tumors involving heart and great vessels". Journal of Korean Medical Science. 28 (5): 717–24. doi:10.3346/jkms.2013.28.5.717. PMC 3653084. PMID 23678263.
- 1 2 Alam L, Agrawal K, Kankanala V, Fishberg R, Powell D (April 2020). "Primary Cardiac Undifferentiated High-Grade Intimal Pleomorphic Sarcoma: A Case Series Report". Cardiology Research. 11 (2): 129–133. doi:10.14740/cr1029. PMC 7092767. PMID 32256920.
- 1 2 Toulmonde M, Lucchesi C, Verbeke S, Crombe A, Adam J, Geneste D, Chaire V, Laroche-Clary A, Perret R, Bertucci F, Bertolo F, Bianchini L, Dadone-Montaudie B, Hembrough T, Sweet S, Kim YJ, Cecchi F, Le Loarer F, Italiano A (December 2020). "High throughput profiling of undifferentiated pleomorphic sarcomas identifies two main subgroups with distinct immune profile, clinical outcome and sensitivity to targeted therapies". eBioMedicine. 62: 103131. doi:10.1016/j.ebiom.2020.103131. PMC 7708794. PMID 33254023.
- ↑ Arora S, Rastogi S, Shamim SA, Barwad A, Sethi M (2020). "Good and sustained response to pembrolizumab and pazopanib in advanced undifferentiated pleomorphic sarcoma: a case report". Clinical Sarcoma Research. 10: 10. doi:10.1186/s13569-020-00133-9. PMC 7346343. PMID 32670543.
- ↑ Arnett AL, Smith TL, Gamez ME, Jhawar SR (August 2021). "Haemichorea-haemiballism secondary to brain metastasis from undifferentiated pleomorphic sarcoma". BMJ Case Reports. 14 (8): e242342. doi:10.1136/bcr-2021-242342. PMC 8378830. PMID 34400423.
- ↑ Lee M, Song JS, Hong SM, Jang SJ, Kim J, Song KB, Lee JH, Cho KJ (May 2020). "Sarcoma metastasis to the pancreas: experience at a single institution". Journal of Pathology and Translational Medicine. 54 (3): 220–227. doi:10.4132/jptm.2020.03.04. PMC 7253956. PMID 32311873.
- ↑ Xu G, Shi X, Shao G (June 2013). "An unusual case of metastasis of a pulmonary undifferentiated pleomorphic sarcoma to the right ventricle: a case report". Journal of Medical Case Reports. 7: 165. doi:10.1186/1752-1947-7-165. PMC 3750226. PMID 23805953.
- 1 2 3 Ishihara S, Yamada Y, Iwasaki T, Yoshimoto M, Toda Y, Kohashi K, Yamamoto H, Matsumoto Y, Nakashima Y, Oda Y (January 2021). "PD‑L1 and IDO‑1 expression in undifferentiated pleomorphic sarcoma: The associations with tumor infiltrating lymphocytes, dMMR and HLA class I". Oncology Reports. 45 (1): 379–389. doi:10.3892/or.2020.7837. hdl:2324/4474987. PMID 33155664. S2CID 226270021.
- ↑ Liang J, Li S, Li W, Rao W, Xu S, Meng H, Zhu F, Zhai D, Cui M, Xu D, Cai J, Zhang B (November 2021). "CMTM6, a potential immunotherapy target". Journal of Cancer Research and Clinical Oncology. 148 (1): 47–56. doi:10.1007/s00432-021-03835-9. PMID 34783871. S2CID 244132643.
- ↑ Ishihara S, Iwasaki T, Kohashi K, Yamada Y, Toda Y, Ito Y, Susuki Y, Kawaguchi K, Takamatsu D, Kawatoko S, Kiyozawa D, Mori T, Kinoshita I, Yamamoto H, Fujiwara T, Setsu N, Endo M, Matsumoto Y, Nakashima Y, Oda Y (July 2021). "The association between the expression of PD-L1 and CMTM6 in undifferentiated pleomorphic sarcoma". Journal of Cancer Research and Clinical Oncology. 147 (7): 2003–2011. doi:10.1007/s00432-021-03616-4. PMID 33811537. S2CID 232773534.
- ↑ Orth MF, Gerke JS, Knösel T, Altendorf-Hofmann A, Musa J, Alba-Rubio R, Stein S, Hölting TL, Cidre-Aranaz F, Romero-Pérez L, Dallmayer M, Baldauf MC, Marchetto A, Sannino G, Knott MM, Wehweck F, Ohmura S, Li J, Hakozaki M, Kirchner T, Dandekar T, Butt E, Grünewald TG (February 2019). "Functional genomics identifies AMPD2 as a new prognostic marker for undifferentiated pleomorphic sarcoma". International Journal of Cancer. 144 (4): 859–867. doi:10.1002/ijc.31903. PMID 30267407. S2CID 52883298.
- ↑ Abeshouse, Adam; et al. (November 2017). "Comprehensive and Integrated Genomic Characterization of Adult Soft Tissue Sarcomas". Cell. 171 (4): 950–965.e28. doi:10.1016/j.cell.2017.10.014. PMC 5693358. PMID 29100075.
- ↑ Anusewicz D, Orzechowska M, Bednarek AK (February 2021). "Notch Signaling Pathway in Cancer-Review with Bioinformatic Analysis". Cancers. 13 (4): 768. doi:10.3390/cancers13040768. PMC 7918426. PMID 33673145.
- ↑ Chu HY, Chen Z, Wang L, Zhang ZK, Tan X, Liu S, Zhang BT, Lu A, Yu Y, Zhang G (2021). "Dickkopf-1: A Promising Target for Cancer Immunotherapy". Frontiers in Immunology. 12: 658097. doi:10.3389/fimmu.2021.658097. PMC 8174842. PMID 34093545.
- 1 2 Delespaul L, Lesluyes T, Pérot G, Brulard C, Lartigue L, Baud J, Lagarde P, Le Guellec S, Neuville A, Terrier P, Vince-Ranchère D, Schmidt S, Debant A, Coindre JM, Chibon F (February 2017). "Recurrent TRIO Fusion in Nontranslocation-Related Sarcomas". Clinical Cancer Research. 23 (3): 857–867. doi:10.1158/1078-0432.CCR-16-0290. PMID 27528700. S2CID 3756473.
- 1 2 Zheng B, Qu Y, Wang J, Shi Y, Yan W (2019). "Pathogenic and Targetable Genetic Alterations in Resected Recurrent Undifferentiated Pleomorphic Sarcomas Identified by Targeted Next-generation Sequencing". Cancer Genomics & Proteomics. 16 (3): 221–228. doi:10.21873/cgp.20127. PMC 6542646. PMID 31018952.
- ↑ Ali NM, Niada S, Brini AT, Morris MR, Kurusamy S, Alholle A, Huen D, Antonescu CR, Tirode F, Sumathi V, Latif F (February 2019). "Genomic and transcriptomic characterisation of undifferentiated pleomorphic sarcoma of bone". The Journal of Pathology. 247 (2): 166–176. doi:10.1002/path.5176. PMC 8033574. PMID 30281149.
- ↑ Fagan RJ, Dingwall AK (August 2019). "COMPASS Ascending: Emerging clues regarding the roles of MLL3/KMT2C and MLL2/KMT2D proteins in cancer". Cancer Letters. 458: 56–65. doi:10.1016/j.canlet.2019.05.024. PMC 6638576. PMID 31128216.
- ↑ Rodrigues GO, Cramer SD, Winer HY, Hixon JA, Li W, Yunes JA, Durum SK (May 2021). "Mutations that collaborate with IL-7Ra signaling pathways to drive ALL". Advances in Biological Regulation. 80: 100788. doi:10.1016/j.jbior.2021.100788. PMID 33578108. S2CID 231908606.
- ↑ Watanabe K, Tajino T, Sekiguchi M, Suzuki T (May 2000). "h-Caldesmon as a specific marker for smooth muscle tumors. Comparison with other smooth muscle markers in bone tumors". American Journal of Clinical Pathology. 113 (5): 663–8. doi:10.1309/jnqx-f4km-q0q0-7xk8. PMID 10800398.
- ↑ Alomari AK, Glusac EJ, McNiff JM (November 2014). "p40 is a more specific marker than p63 for cutaneous poorly differentiated squamous cell carcinoma". Journal of Cutaneous Pathology. 41 (11): 839–45. doi:10.1111/cup.12388. PMID 25263848. S2CID 9053425.
- ↑ Gleason BC, Nascimento AF (February 2007). "HMB-45 and Melan-A are useful in the differential diagnosis between granular cell tumor and malignant melanoma". The American Journal of Dermatopathology. 29 (1): 22–7. doi:10.1097/01.dad.0000249888.41884.6c. PMID 17284958. S2CID 20167145.
- 1 2 3 Gronchi A, Ferrari S, Quagliuolo V, Broto JM, Pousa AL, Grignani G, Basso U, Blay JY, Tendero O, Beveridge RD, Ferraresi V, Lugowska I, Merlo DF, Fontana V, Marchesi E, Donati DM, Palassini E, Palmerini E, De Sanctis R, Morosi C, Stacchiotti S, Bagué S, Coindre JM, Dei Tos AP, Picci P, Bruzzi P, Casali PG (June 2017). "Histotype-tailored neoadjuvant chemotherapy versus standard chemotherapy in patients with high-risk soft-tissue sarcomas (ISG-STS 1001): an international, open-label, randomised, controlled, phase 3, multicentre trial". The Lancet. Oncology. 18 (6): 812–822. doi:10.1016/S1470-2045(17)30334-0. PMID 28499583.
- ↑ Savina M, Le Cesne A, Blay JY, Ray-Coquard I, Mir O, Toulmonde M, Cousin S, Terrier P, Ranchere-Vince D, Meeus P, Stoeckle E, Honoré C, Sargos P, Sunyach MP, Le Péchoux C, Giraud A, Bellera C, Le Loarer F, Italiano A (April 2017). "Patterns of care and outcomes of patients with METAstatic soft tissue SARComa in a real-life setting: the METASARC observational study". BMC Medicine. 15 (1): 78. doi:10.1186/s12916-017-0831-7. PMC 5385590. PMID 28391775.
- ↑ Mazarico Gallego JM, Herrera Juárez M, Paz-Ares L (March 2020). "The safety and efficacy of pembrolizumab for the treatment of non-small cell lung cancer". Expert Opinion on Drug Safety. 19 (3): 233–242. doi:10.1080/14740338.2020.1736554. PMID 32129104. S2CID 212405175.
- ↑ Keung EZ, Burgess M, Salazar R, Parra ER, Rodrigues-Canales J, Bolejack V, Van Tine BA, Schuetze SM, Attia S, Riedel RF, Hu J, Okuno SH, Priebat DA, Movva S, Davis LE, Reed DR, Reuben A, Roland CL, Reinke D, Lazar AJ, Wang WL, Wargo JA, Tawbi HA (March 2020). "Correlative Analyses of the SARC028 Trial Reveal an Association Between Sarcoma-Associated Immune Infiltrate and Response to Pembrolizumab". Clinical Cancer Research. 26 (6): 1258–1266. doi:10.1158/1078-0432.CCR-19-1824. PMC 7731262. PMID 31900276.
- ↑ Monga V, Skubitz KM, Maliske S, Mott SL, Dietz H, Hirbe AC, Van Tine BA, Oppelt P, Okuno S, Robinson S, O'Connor M, Seetharam M, Attia S, Charlson J, Agulnik M, Milhem M (July 2020). "A Retrospective Analysis of the Efficacy of Immunotherapy in Metastatic Soft-Tissue Sarcomas". Cancers. 12 (7): 1873. doi:10.3390/cancers12071873. PMC 7408640. PMID 32664595.
- ↑ Toulmonde M, Penel N, Adam J, Chevreau C, Blay JY, Le Cesne A, Bompas E, Piperno-Neumann S, Cousin S, Grellety T, Ryckewaert T, Bessede A, Ghiringhelli F, Pulido M, Italiano A (January 2018). "Use of PD-1 Targeting, Macrophage Infiltration, and IDO Pathway Activation in Sarcomas: A Phase 2 Clinical Trial". JAMA Oncology. 4 (1): 93–97. doi:10.1001/jamaoncol.2017.1617. PMC 5833654. PMID 28662235.
- ↑ Keung EZ, Lazar AJ, Torres KE, Wang WL, Cormier JN, Ashleigh Guadagnolo B, Bishop AJ, Lin H, Hunt KK, Bird J, Lewis VO, Patel SR, Wargo JA, Somaiah N, Roland CL (September 2018). "Phase II study of neoadjuvant checkpoint blockade in patients with surgically resectable undifferentiated pleomorphic sarcoma and dedifferentiated liposarcoma". BMC Cancer. 18 (1): 913. doi:10.1186/s12885-018-4829-0. PMC 6154892. PMID 30249211.